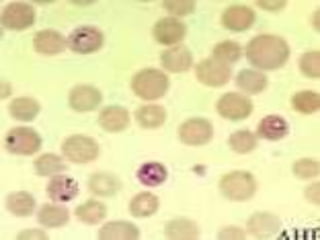

This document provides information about bovine babesiosis, a tick-borne disease caused by the protozoan parasite Babesia. It affects cattle and is transmitted by ticks. The most important species are B. bovis, B. bigemina, and B. divergens. Clinical signs include fever, anemia, jaundice, and red urine. Severe cases can cause death. Diagnosis involves finding the parasites on blood smears. Control relies on tick control, vaccination, and treatment of infected cattle. Babesiosis can also infect humans in some areas.